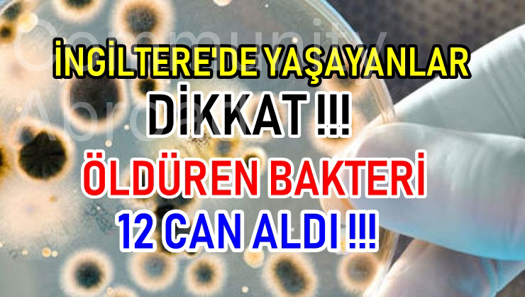

. Towntalk
bar_chart1094
remove_red_eye405
. Events
bar_chart830
remove_red_eye316
BELÇİKA'DA ALARM !!!
Bugün Belçika Afrika, çöl sıcaklarına teslim oldu. Belçika'da sıcaklık 34 derece olarak açıklandı.

. Towntalk
bar_chart1141
remove_red_eye830
. Marketplace
bar_chart737
remove_red_eye321
. Jobs
bar_chart1105
remove_red_eye329